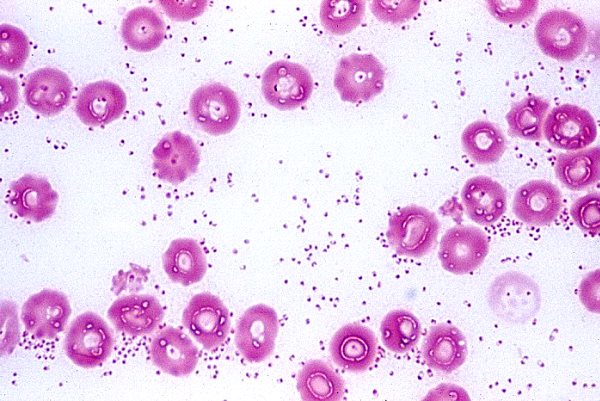

Nội dung
Bệnh Tụ huyết trùng lợn là một trong những căn bệnh có thể chấm dứt mọi tính toán kiếm lời từ chăn nuôi lợn của một người nông dân. Đối tượng dễ bị nhiễm bệnh này nhất là lợn con, chúng thường được nuôi để bán. Lợn trưởng thành cũng bị bệnh, nhưng ít thường xuyên hơn và dễ chịu bệnh hơn lợn con.
Đây là bệnh gì "tụ huyết trùng"
Bệnh vi khuẩn này được coi là phổ biến ở nhiều loài động vật, bao gồm cả con người. Sau này thường bị nhiễm Pasteurella từ vật nuôi. Tác nhân gây bệnh cho lợn là vi khuẩn bất động Pasteurella multocida týp A và D và Pasteurella haemolytica. Các dấu hiệu của bệnh tụ huyết trùng rất khác nhau tùy thuộc vào loài động vật mà vi khuẩn được nuôi cấy.
Pasteurella có 4 nhóm huyết thanh được phân loại: A, B, D, E. Tất cả các nhóm này đều giống nhau về ngoại hình và đặc tính kháng nguyên. Pasteurella trông giống như những que hình bầu dục bất động dài 1,5-0,25 micromet. Đề cập đến vi khuẩn gram âm. Không tạo thành tranh chấp. Tất cả các giống Pasteurella đều phát triển trên cùng một môi trường dinh dưỡng, thích sự hiện diện của máu trong nước dùng.
Pasteurella không có khả năng chống chịu cao:
- khi khô, chết sau một tuần;
- trong phân, nước lạnh và máu có thể sống đến 3 tuần;
- trong xác chết - 4 tháng;
- trong thịt đông lạnh, chúng vẫn có thể tồn tại đến một năm;
- khi đun nóng đến 80 ° C, chúng chết trong 10 phút.
Vi khuẩn không có khả năng chống lại chất khử trùng.
Sự nguy hiểm của bệnh là gì
Bệnh tụ huyết trùng thường phát triển theo con đường của dịch bệnh. Ngay sau khi nhiễm bệnh cho một cá thể, tất cả lợn trong trang trại đều bị bệnh. Thông thường, lợn con quan sát thấy một đợt bệnh tụ huyết trùng cấp tính và tăng cấp tính. Ở lợn trưởng thành, một quá trình mãn tính được tìm thấy. Do đặc thù của quá trình bệnh tụ huyết trùng mãn tính, con vật thường được điều trị các bệnh khác, góp phần làm lây lan bệnh tụ huyết trùng.
Nguyên nhân và cách lây nhiễm
Vi khuẩn được bài tiết ra ngoài cùng với dịch sinh lý của con vật bị bệnh. Những người mang trực khuẩn có thể là những con lợn khỏe mạnh bề ngoài, nhưng những con lợn đã hồi phục. Sự lây nhiễm xảy ra khi tiếp xúc trực tiếp với động vật bởi các giọt nhỏ trong không khí. Ngoài ra, một con lợn khỏe mạnh có thể bị tụ huyết trùng qua nước và thức ăn bị nhiễm phân hoặc nước bọt. Vật mang bệnh tụ huyết trùng có thể là côn trùng hút máu.
Việc bảo quản vi khuẩn ở môi trường bên ngoài được tạo điều kiện thuận lợi bởi:
- vệ sinh máy móc không kịp thời, điều này góp phần làm tăng độ ẩm do nước tiểu bay hơi;
- thức ăn kém chất lượng làm giảm khả năng miễn dịch của lợn;
- Quá đông vật nuôi, do đó lợn bị căng thẳng, cũng dẫn đến suy giảm hệ thống miễn dịch;
- thiếu vitamin trong chế độ ăn uống.
Cũng có những đợt bùng phát bệnh tụ huyết trùng sau khi tiêm vắc xin phòng bệnh dịch hạch và bệnh viêm quầng.
Các triệu chứng của bệnh ở các dạng khác nhau
Tụ huyết trùng là một bệnh “hay biến”. Các dấu hiệu của nó thay đổi không chỉ tùy thuộc vào loại tiến trình của bệnh. Tổng cộng, có 4 loại diễn biến của bệnh:
- siêu nét;
- vị cay;
- bán cấp tính;
- mãn tính.
Chúng khác nhau về khoảng thời gian trôi qua từ khi xuất hiện các triệu chứng đầu tiên cho đến khi lợn chết.Bệnh tụ huyết trùng xảy ra như thế nào ở từng con lợn cụ thể phụ thuộc vào độc lực của vi khuẩn và sức đề kháng của hệ thống miễn dịch của vật nuôi đối với tác nhân gây bệnh.
Dạng hyperacute
Với thể tụ huyết trùng siêu vi, lợn chết sau vài giờ. Dấu hiệu của một dạng cường độ cao:
- nhiệt độ 41-42 ° C;
- khát nước;
- từ chối cho ăn;
- trạng thái chán nản;
- rối loạn trong công việc của hệ thống tim mạch và hô hấp;
- có thể tiêu chảy lẫn máu và chất nhầy.
Bệnh tiến triển rất nhanh. Trước khi chết lợn có triệu chứng suy tim, sưng phù đầu. Trong các nghiên cứu bệnh lý, phù phổi được phát hiện.
Hình thức cấp tính
Các triệu chứng của dạng cấp tính cũng giống như đối với dạng tăng tiết. Trước khi chết và trong quá trình nghiên cứu, những dấu hiệu tương tự cũng được tìm thấy. Không giống như hyperacute, với đợt tụ huyết trùng này, tử vong xảy ra sau vài ngày.
Dạng bán cấp tính
Diễn biến bệnh tụ huyết trùng bán cấp và mãn tính cũng tương tự. Trong cả hai trường hợp, bệnh được đặc trưng bởi sốt và khu trú của quá trình trong các hệ thống riêng lẻ của cơ thể lợn. Tùy thuộc vào khu trú của vi khuẩn, bệnh tụ huyết trùng được chia thành 3 dạng:
Đường ruột:
- tiêu chảy suy nhược với phân màu nâu sẫm hoặc hơi đỏ;
- phụ gia của máu trong phân;
- khát nước;
- từ chối cho ăn;
- kiệt sức;
Pectoral:
- huyết thanh, sau đó chảy nước mũi nhầy;
- có thể có máu trong nước mũi;
- thở gấp;
- ho;
Edematous:
- sưng viêm mí mắt;
- sưng lưỡi và thanh quản;
- sưng tấy mô dưới da ở cổ, bụng và chân;
- khó nuốt;
- hơi thở khó khăn;
- tiết nước bọt đặc;
- suy tim.
Do các triệu chứng của bệnh tụ huyết trùng rất đa dạng nên bệnh này có thể dễ bị nhầm lẫn với các bệnh nhiễm trùng khác.
Dạng mãn tính
Các triệu chứng và khu trú của vi khuẩn trong quá trình mãn tính tương tự như bán cấp tính. Nhưng vì cái chết xảy ra sau một vài tuần, nhiều thay đổi bệnh lý hơn có thời gian tích lũy:
- sự suy kiệt của xác chết;
- viêm ruột xuất huyết dạng sợi;
- viêm mủ-xơ có hoại tử ở phổi.
Vì trong giai đoạn bán cấp và mãn tính của bệnh tụ huyết trùng, các triệu chứng ở lợn phụ thuộc vào sự khu trú của vi khuẩn, do đó việc điều trị chỉ được kê đơn sau khi phân biệt với bệnh dịch hạch, bệnh viêm quầng và bệnh salmonellosis.
Bệnh được chẩn đoán như thế nào?
Nếu nghi ngờ mắc bệnh tụ huyết trùng, các bộ phận của xác lợn chết được giao cho phòng thí nghiệm để nghiên cứu. Toàn bộ thân thịt không cần thiết trong phòng thí nghiệm, vì bệnh tụ huyết trùng ảnh hưởng đến các cơ quan nội tạng. Khi khám nghiệm tử thi, các tổn thương được tìm thấy:
- Đường tiêu hóa;
- phổi;
- cơ tim;
- lách;
- Gan.
Bức ảnh chụp một lá phổi của một con lợn bị chết do tụ huyết trùng.
Ngoài phổi và lá lách, bạn cũng có thể gửi nghiên cứu đến phòng thí nghiệm:
- óc;
- các tuyến;
- hạch bạch huyết;
- xương hình ống.
Sau khi nhận được vật liệu sinh học trong phòng thí nghiệm, việc phân lập pasteurella và xét nghiệm sinh học trên chuột cũng được thực hiện.
Những mảnh nội tạng nhỏ có kích thước 5x5 cm được bàn giao để phân tích. Chỉ những vật liệu từ những động vật không có thời gian tiếp nhận thuốc kháng sinh trong suốt cuộc đời của chúng mới phù hợp để nghiên cứu.
Điều trị bệnh tụ huyết trùng ở lợn
Lợn ốm được tách ra và đặt trong phòng khô ráo, ấm áp. Cung cấp thức ăn hoàn chỉnh với thức ăn chất lượng cao. Điều trị được thực hiện một cách toàn diện, sử dụng các loại thuốc kháng khuẩn và các bài thuốc để điều trị triệu chứng. Trong số các loại thuốc kháng sinh, những thuốc thuộc nhóm penicillin và tetracycline được ưu tiên hơn cả. Thuốc kháng sinh được sử dụng theo hướng dẫn của thuốc. Một số loại thuốc tác dụng kéo dài có thể được sử dụng một lần, nhưng điều này nên được chỉ định trong hướng dẫn. Thuốc sulfanilamide cũng được sử dụng.
Để tăng cường khả năng miễn dịch, huyết thanh chống tụ huyết trùng lợn được sử dụng. Nó được dùng một lần tiêm bắp hoặc tiêm tĩnh mạch với liều 40 ml cho mỗi con.
Khi bán, bạn có thể tìm thấy whey sản xuất của Belarus và Armavir. Từ các hướng dẫn, sự khác biệt giữa hai loại thuốc này là ở thời điểm hình thành miễn dịch thụ động và thời điểm bảo vệ chống lại bệnh tụ huyết trùng.
Sau khi sử dụng huyết thanh sản xuất Armavir, khả năng miễn dịch được hình thành trong vòng 12-24 giờ và kéo dài trong 2 tuần. Ở Belarus, khả năng miễn dịch được hình thành ngay sau khi áp dụng, nhưng nó chỉ kéo dài 1 tuần.
Khi có động vật bị bệnh trong trang trại, huyết thanh từ bệnh tụ huyết trùng lợn cũng được sử dụng như một chất dự phòng cho những con vật trông khỏe mạnh. Lợn con khỏe mạnh về mặt lâm sàng dưới một con lợn nái ốm được tiêm huyết thanh với liều lượng điều trị.
Nếu phát hiện bệnh tụ huyết trùng trong trang trại thì trang trại đó được kiểm dịch. Việc xuất nhập lợn bên ngoài trang trại bị cấm. Xác lợn bị giết mổ cưỡng bức được đưa đến nhà máy chế biến thịt để xử lý.
Dự phòng
Phòng bệnh tụ huyết trùng trước hết là tuân thủ các quy tắc thú y. Lợn mới mua về được kiểm dịch trong 30 ngày. Vật nuôi được tuyển chọn từ các trang trại không bị bệnh tụ huyết trùng. Không cho phép tiếp xúc giữa những con lợn từ các đàn khác nhau.
Lợn không chăn thả trên đồng cỏ ngập nước, nơi mầm bệnh tụ huyết trùng có thể tồn tại trong sáu tháng. Họ thực hiện thường xuyên việc phân loại mặt bằng. Bảo quản thức ăn được thực hiện trong các hộp kín không thể tiếp cận với các loài gặm nhấm.
Ở những vùng không thuận lợi với bệnh tụ huyết trùng, việc tiêm phòng bắt buộc cho lợn được thực hiện 2 lần / năm. Tại các trang trại có báo cáo về bệnh tụ huyết trùng, lợn mới phải được tiêm phòng tại nhà cung cấp trong năm hoặc tiêm phòng khi kiểm dịch. Không được phép đưa động vật chưa được tiêm phòng vào đàn không sớm hơn một năm sau khi trang trại đã được phục hồi.
Vắc xin phòng bệnh tụ huyết trùng
Huyết thanh được tạo ra từ máu của động vật đã được phục hồi hoặc đã được tiêm phòng. Nó chứa các kháng thể đối với bệnh tụ huyết trùng và có tác dụng ngay sau khi dùng.
Vắc xin - một chế phẩm có chứa vi khuẩn pasteurella, được vô hiệu hóa bởi formalin. Không nên sử dụng vắc-xin này ở trang trại đã phát hiện bệnh tụ huyết trùng. Trong trường hợp này, tiêm chủng có thể kích thích sự phát triển của bệnh.
Ở những trang trại nằm ở vùng khó khăn hoặc trước đó đã từng tồn tại dịch bệnh tụ huyết trùng, việc tiêm phòng cho lợn là bắt buộc. Chỉ những động vật khỏe mạnh về mặt lâm sàng mới được tiêm phòng.
Thực hiện tiêm phòng 2 lần. Sự hình thành miễn dịch xảy ra 20-25 ngày sau lần tiêm chủng cuối cùng. Khả năng miễn dịch được duy trì trong 6 tháng.
Lợn nái được tiêm phòng truyền lại khả năng miễn dịch cho lợn con. Tác động của miễn dịch “sữa” như vậy kéo dài 1 tháng, do đó, từ 20-25 ngày tuổi, lợn con được tiêm phòng hai lần, cách nhau 20-40 ngày. Thuốc tiêm được tiêm bắp vào cổ. Liều cho lợn con là 0,5 ml.
Tử cung mang thai được tiêm phòng một liều kép (1 ml) 1-1,5 tháng trước khi đẻ. Vắc xin được tiêm bắp vào một phần ba trên của cổ.
Phần kết luận
Bệnh tụ huyết trùng lợn là bệnh có thể tránh được nếu tuân thủ các điều kiện về chuồng trại và khẩu phần ăn của chúng. Tiêm phòng kịp thời sẽ làm giảm đáng kể khả năng mắc bệnh tụ huyết trùng, vì các tác nhân gây bệnh này là như nhau ở tất cả các loài động vật. Không thể dựa vào một con lợn để bị nhiễm bệnh từ gà hoặc thỏ.